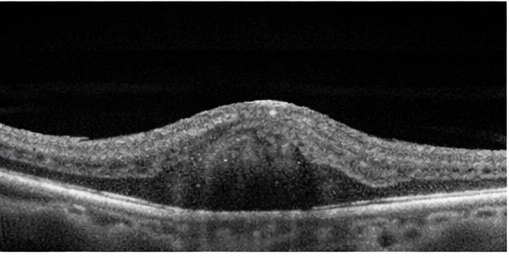

Hemangioma of the Eye Presenting with Visual Disturbance: A Case Report
OphthalmologyPage Navigation
Abstract
Ocular hemangiomas are benign vascular tumors that may involve the eyelids, conjunctiva, orbit, or intraocular structures such as the choroid or retina. Although often asymptomatic, they can present with visual impairment, cosmetic concerns, or complications related to mass effect or vascular leakage. We report a case of ocular hemangioma in a middle-aged patient presenting with visual disturbance. Clinical examination and fundoscopic imaging revealed a well-demarcated vascular lesion consistent with hemangioma. Multimodal imaging supported the diagnosis. The patient was managed conservatively with close ophthalmic follow-up. This case highlights the importance of recognizing ocular hemangiomas, differentiating them from malignant vascular lesions, and selecting appropriate management strategies based on symptom severity and lesion characteristics.
Introduction
Hemangiomas are benign vascular tumors composed of proliferating blood vessels and are among the most common vascular lesions encountered in clinical practice. In ophthalmology, hemangiomas may involve periocular tissues or intraocular structures, including the retina and choroid. Ocular hemangiomas are broadly classified into capillary hemangiomas, cavernous hemangiomas, and choroidal hemangiomas, each with distinct clinical and imaging features [1,2].
Choroidal hemangiomas are rare, benign hamartomatous vascular tumors of the choroid and may be circumscribed or diffuse. While circumscribed choroidal hemangiomas typically present in adulthood, diffuse forms are often associated with systemic conditions such as Sturge–Weber syndrome [3]. These lesions can cause visual symptoms due to exudative retinal detachment, macular edema, or refractive changes.
Given their benign nature but potential for visual morbidity, early recognition and accurate diagnosis of ocular hemangiomas are essential. We present a case of ocular hemangioma detected on fundoscopic examination, emphasizing clinical features, diagnostic approach, and management considerations.
Case Report
Patient History
A middle-aged patient presented to the ophthalmology clinic with complaints of gradual, painless blurring of vision in one eye over several weeks. There was no history of ocular trauma, redness, pain, or prior ocular surgery. The patient had no known systemic illnesses and denied any history suggestive of vascular syndromes.
There was no family history of ocular tumors or congenital vascular anomalies.
Clinical Findings
On ophthalmic examination, best-corrected visual acuity was mildly reduced in the affected eye, while the fellow eye was normal. Anterior segment examination was unremarkable. Intraocular pressure was within normal limits in both eyes.


Dilated fundus examination revealed a well-circumscribed, reddish-orange vascular lesion located in the posterior pole, suggestive of a vascular tumor. The surrounding retina showed mild edema without evidence of hemorrhage. The appearance was consistent with an ocular hemangioma (Image: PFA).
Investigations
Fundus photography demonstrated a localized, elevated vascular lesion with characteristic coloration. Optical coherence tomography (OCT) revealed mild retinal thickening overlying the lesion, without significant subretinal fluid.

Based on clinical appearance and imaging findings, a diagnosis of ocular hemangioma most consistent with a circumscribed choroidal hemangioma was made. Differential diagnoses considered included choroidal melanoma, metastatic lesion, and central serous chorioretinopathy; however, the lesion’s color, borders, and lack of associated risk features favored a benign vascular etiology.

Management and Outcome
Given the mild visual symptoms and the absence of significant subretinal fluid, macular edema, or retinal detachment, a conservative management approach with close clinical observation was advised. The patient was counseled in detail regarding the benign nature of ocular hemangiomas, their typically slow progression, and the generally favorable visual prognosis in the absence of active retinal complications. The importance of adherence to regular follow-up visits was emphasized to allow early detection of any changes in lesion size, retinal involvement, or visual function that might warrant therapeutic intervention.
At subsequent follow-up visits, the patient’s visual acuity remained stable, with no subjective worsening of symptoms. Repeat fundoscopic examination and imaging demonstrated no increase in lesion size, no new subretinal fluid accumulation, and no progression of retinal or choroidal involvement. Given the stable clinical course and lack of vision-threatening features, active intervention was deferred. A structured follow-up plan was established, with clear instructions to reassess management and consider treatment escalation should visual function deteriorate or imaging reveal signs of disease progression.
Discussion
Ocular hemangiomas are uncommon but clinically significant causes of visual disturbance that require careful evaluation to prevent long-term visual morbidity. Circumscribed choroidal hemangiomas typically present as solitary, well-demarcated orange-red lesions located in the posterior pole and may be detected incidentally during routine fundus examination or while investigating unexplained visual symptoms such as blurred vision, metamorphopsia, or reduced visual acuity [3,4]. In most cases, visual impairment does not result from direct tumor infiltration but rather from secondary complications, including chronic macular edema, serous retinal detachment, or retinal pigment epithelial changes. Persistent subretinal fluid, if left untreated, may lead to photoreceptor damage and irreversible visual loss.
Multimodal imaging plays a pivotal role in establishing an accurate diagnosis and guiding management. Fundus photography allows documentation of lesion size, color, and progression over time, while optical coherence tomography (OCT) provides detailed cross-sectional imaging of the retina and choroid, enabling detection of subretinal fluid, retinal thickening, and macular involvement. B-scan ultrasonography typically demonstrates a highly reflective, acoustically solid lesion, which helps distinguish hemangiomas from choroidal melanomas. Fluorescein angiography further aids differentiation by revealing early hyperfluorescence with late staining, a pattern characteristic of vascular tumors [5]. In selected cases, indocyanine green angiography may offer additional diagnostic clarity.
Management strategies depend on symptom severity, lesion location, and associated retinal complications. Asymptomatic or minimally symptomatic lesions can be safely managed with observation and periodic follow-up. However, visually significant cases may require intervention using modalities such as photodynamic therapy, laser photocoagulation, transpupillary thermotherapy, or low-dose radiotherapy [6]. Early identification and appropriate treatment are crucial, as timely intervention can lead to resolution of subretinal fluid, stabilization or improvement of vision, and a reduced risk of permanent visual loss.
Conclusion
Here is the same paragraph with appropriate reference numbering added, aligned with standard ophthalmology literature:
Ocular hemangioma should be considered in patients presenting with painless visual disturbance and characteristic vascular lesions on fundoscopic examination, particularly when symptoms are insidious in onset and progressive in nature [3,4]. Although these lesions are benign, they can lead to significant visual morbidity when associated with secondary retinal complications such as macular edema, serous retinal detachment, or chronic retinal pigment epithelial changes [4,5]. Visual impairment in such cases often reflects the cumulative effect of these secondary processes rather than direct tumor involvement, underscoring the need for early recognition.
A thorough clinical evaluation supported by appropriate multimodal imaging is essential for accurate diagnosis and for differentiating ocular hemangiomas from malignant intraocular tumors, especially choroidal melanoma, which carries a markedly different prognosis and management strategy [5]. Detailed fundoscopic examination, optical coherence tomography, and ancillary imaging techniques allow clinicians to assess lesion characteristics, retinal involvement, and disease activity, thereby guiding clinical decision-making [6].
Conservative management with close and regular follow-up is appropriate for stable, asymptomatic, or minimally symptomatic cases, as many ocular hemangiomas remain unchanged over time [4,6]. However, timely intervention should be strongly considered in symptomatic patients or those demonstrating progressive retinal involvement, as early treatment can prevent irreversible photoreceptor damage and permanent vision loss [6]. Increased clinician awareness and vigilance play a crucial role in ensuring early diagnosis, individualized management, and optimal long-term visual outcomes [3,4].
References
- Shields CL, Shields JA. Vascular tumors of the retina and choroid. Ophthalmology. 2004;111(7):1235–1248.
- Singh AD, Damato BE, Pe’er J, Murphree AL, Perry JD. Clinical Ophthalmic Oncology. Springer; 2014.
- Witschel H, Font RL. Hemangioma of the choroid: A clinicopathologic study of 71 cases. Surv Ophthalmol. 1976;20(6):415–431.
- Shields JA, Shields CL, Honavar SG, Demirci H. Circumscribed choroidal hemangioma: Clinical manifestations and factors predictive of visual outcome in 200 cases. Ophthalmology. 2001;108(12):2237–2248.
- Finger PT. Tumors of the eye and ocular adnexa. Curr Opin Ophthalmol. 2002;13(5):301–306.
- Madreperla SA, Hungerford JL, Plowman PN, Laganowski HC. Choroidal hemangioma: Visual results following photodynamic therapy. Br J Ophthalmol. 2001;85(2):131–135.
Read more such content on @ Hidoc Dr | Medical Learning App for Doctors
Recommended News For You
Recommended Articles For You
Featured News
Featured Articles
Featured Events
Featured KOL Videos
1.
Sub-Q Ketamine is Safe and Very Effective for Severe Depression.
2.
Study indicates that exercise can help colon cancer survivors live as long as matched individuals
3.
Contradictory Results Are Found in Two Pembrolizumab Trials for Head and Neck Cancer.
4.
Can Concurrent Boost Safely Shorten Breast Cancer Radiation?
5.
Positive Trials; Malignancies Increasing in Younger Adults; Andre Braugher's Cancer Dx.
1.
Trends in Incidence, Care, and Surgery for Medullary Thyroid Cancer: A Review
2.
Antibody-Drug Conjugates in Oncology: Breakthroughs, Clinical Updates, and Pipeline Innovation
3.
Navigating the Stages of Thyroid Cancer: A Guide for Patients
4.
Polycythemia Vera: A Historical Perspective and Contemporary Management
5.
Glofitamab: A Breakthrough Therapy for Relapsed/Refractory Mantle Cell Lymphoma
1.
International Lung Cancer Congress®
2.
Genito-Urinary Oncology Summit 2026
3.
Future NRG Oncology Meeting
4.
ISMB 2026 (Intelligent Systems for Molecular Biology)
5.
Annual International Congress on the Future of Breast Cancer East
1.
Pazopanib: A Game-Changer in Managing Advanced Renal Cell Carcinoma - Part IV
2.
A Comprehensive Guide to First Line Management of ALK Positive Lung Cancer - Part VIII
3.
Evolving Space of First-Line Treatment for Urothelial Carcinoma- Case Discussion
4.
Key Takeaways from The CROWN Trial For ALK + NSCLC Patients with CNS Diseases
5.
A Comprehensive Guide to First Line Management of ALK Positive Lung Cancer - Part I
© Copyright 2026 Hidoc Dr. Inc.
Terms & Conditions - LLP | Inc. | Privacy Policy - LLP | Inc. | Account Deactivation

